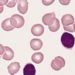
Combined lenalidomide and rituximab dose escalation found to be safe for CLL

#VisualAbstract: Omalizumab is superior to placebo in reducing the reaction threshold for patients with multiple food allergies
 Click here to read this study in NEJM.
Click here to read this study in NEJM.
©2024 2 Minute Medicine, Inc. All rights reserved. No works may be reproduced without expressed written consent from 2 Minute Medicine, Inc. Inquire about licensing here. No article should be construed as medical advice and is not intended as such by the authors or by 2 Minute Medicine, Inc.